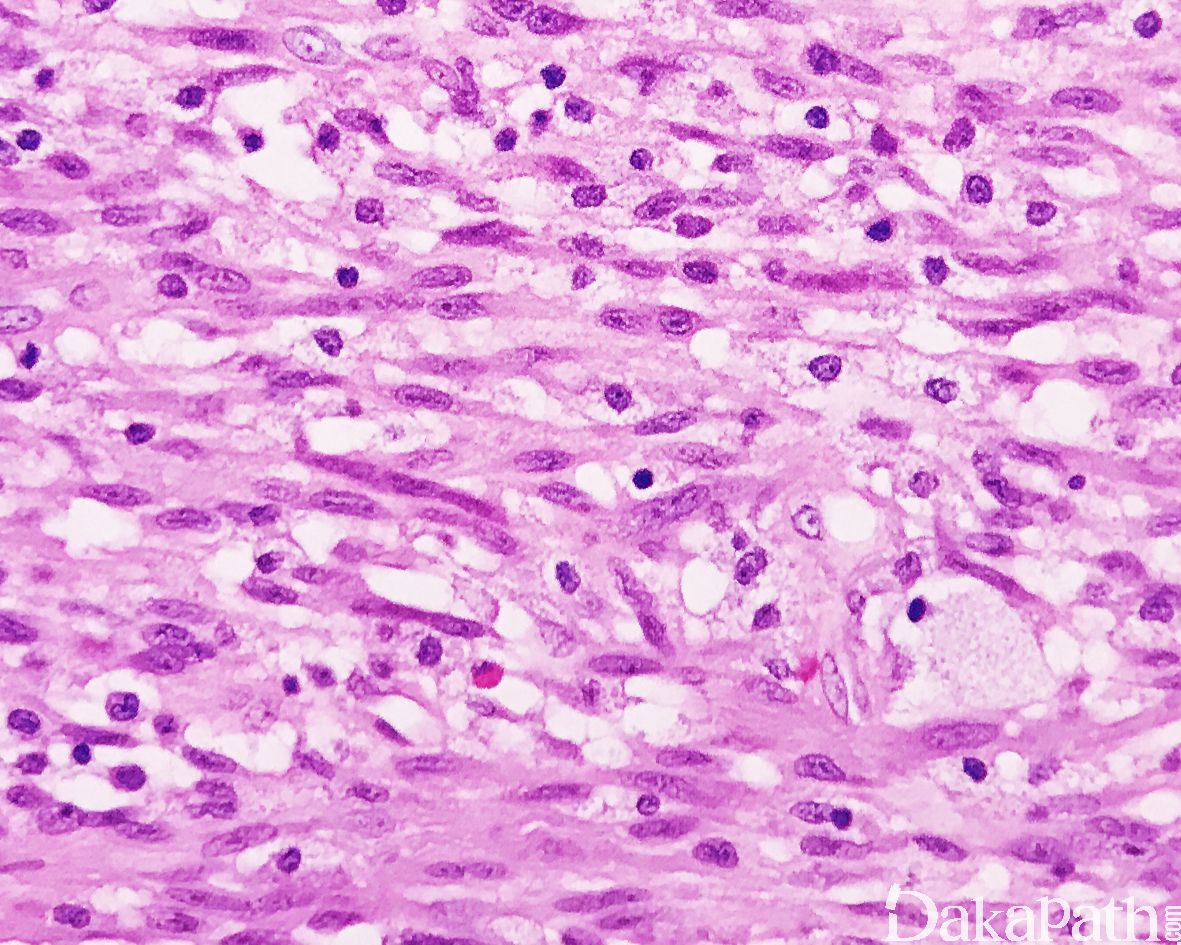

梭形细胞横纹肌肉瘤
Spindle Cell Rhabdomyosarcoma
发病部位: 睾丸旁,头颈部,膀胱、腹部和四肢软组织
诊断要点:
好发于儿童和青少年,男性多见,最常见于睾丸旁,其次为头颈部,肿瘤呈结节状,界限清楚,无包膜;
镜下见由长梭形细胞呈束状排列,也可呈席纹状、交织的束状或漩涡状排列,或呈波浪状排列;
细胞质强嗜酸性,原纤维状,核呈长卵圆形,两端稍钝,多数病例可见散在的横纹肌母细胞;
瘤细胞的异型性不明显,可见少数核分裂像;
少数病例可见典型的原始胚胎性横纹肌肉瘤成分;
间质可见数量不等的胶原纤维。

免疫组织化学染色:
MSA、desmin、myogenin 和 MyoD 1 阳性,可表达 CD56
分子标记:
先天性(出生或 1 岁以内)硬化性横纹肌肉瘤常见肌特异性基因的融合包括(VGLL2, TEAD1, 和 SRF)等,通常预后非常好;1 岁以上的硬化性横纹肌肉瘤约 67%可见 MYOD1 基因突变,高度侵袭性;无融合基因或 MYOD1 基因突变的硬化性横纹肌肉瘤的预后介于两者之间。
鉴别诊断:
肌纤维母细胞肉瘤
纤维肉瘤
MPNST
| 肿瘤类型 | Myogenin | Desmin | SMA | H-caldesmon | S100 | GFAP |
| 梭形细胞横纹肌肉瘤 | ++ | + | +/- | - | - | - |
| 平滑肌肉瘤 | - | + | ++ | + | - | -/+ |
| 低级别肌纤维母细胞肉瘤 | - | +/- | + | - | - | - |
| 纤维肉瘤 | - | - | +/- | - | - | - |
| MPNST | - | - | - | - | +/- | +/- |
| 促纤维增生性恶性黑色素瘤 | - | - | - | - | ++ | +/- |
预后:
先天性(出生或 1 岁以内)硬化性/梭形细胞横纹肌肉瘤常见肌特异性基因的融合包括(VGLL2, TEAD1, 和 SRF)等,通常预后非常好;1 岁以上的硬化性/梭形细胞横纹肌肉瘤约 67%可见 MYOD1 基因突变,高度侵袭性;无融合基因或 MYOD1 基因突变的硬化性/梭形细胞横纹肌肉瘤的预后介于两者之间。
治疗:
手术完整切除,伴或不伴术后辅助治疗
病例报道:
Fernando V J, Fernández N, Gómezromán J J. Spindle cell rhabdomyosarcoma in adults. A case report and literature review.[J]. Pathology - Research and Practice, 2000, 196(1):67-72. 参考文献:
Carroll S J, Nodit L. Spindle cell rhabdomyosarcoma: a brief diagnostic review and differential diagnosis[J]. Archives of Pathology & Laboratory Medicine, 2013, 137(8):1155-1158. Nascimento A F, Fletcher C D. Spindle cell rhabdomyosarcoma in adults[J]. American Journal of Surgical Pathology, 2005, 29(8):1106-1113. Agaram NP, LaQuaglia MP, Alaggio R, et al. MYOD1-mutant spindle cell and sclerosing rhabdomyosarcoma: an aggressive subtype irrespective of age. A reappraisal for molecular classification and risk stratification. Mod Pathol 2018.
